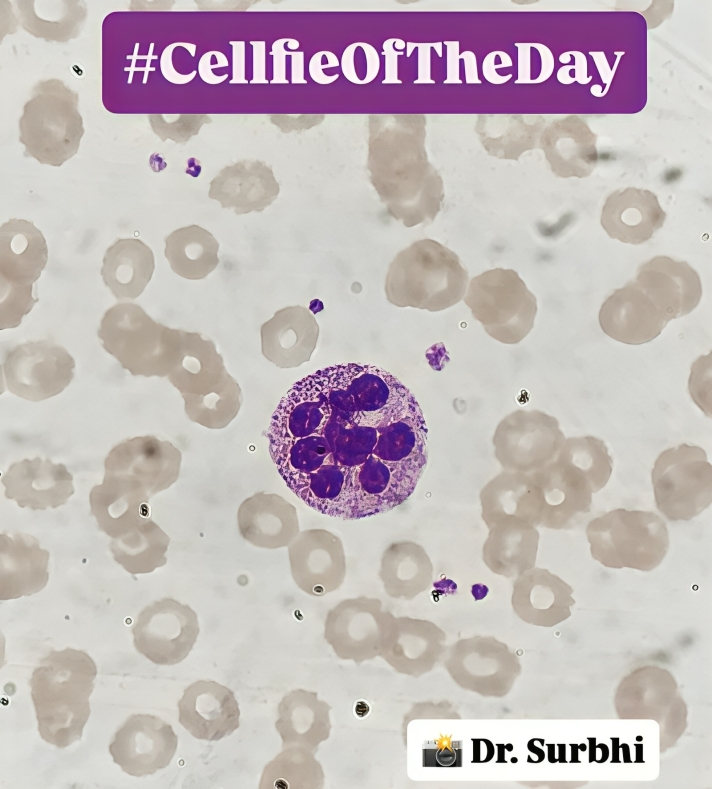
Surbhi Singh

Surbhi Singh/LinkedIn
Oct 28, 2025, 06:54
Surbhi Singh: Hypersegmented Neutrophils – The Overachievers of the Myeloid World
Surbhi Singh, Consultant Haematopathology at Agilus Diagnostics and Fortis Hospital Gurugram, shared a post on LinkedIn:
“Hypersegmented Neutrophils
Meet the overachievers of the myeloid world!
Neutrophils with ≥5 lobes, flagging a nuclear maturation defect — most classically in megaloblastic anemia (B12 or folate deficiency) when the nucleus keeps dividing but the cytoplasm doesn’t keep pace.
Clue: If more than 5% of neutrophils have 5 lobes or any one neutrophil has ≥6 — time to think B12/folate deficiency.
Other Causes of Hypersegmented Neutrophils
- Myelodysplastic syndromes (MDS)
- Chemotherapy / cytotoxic drugs (e.g., methotrexate, hydroxyurea)
- DNA synthesis inhibitors (e.g., azathioprine, 5-FU)
- Chronic infections / inflammation
- Congenital neutrophil disorders (rare)
- Uremia (occasionally)
- Alcoholism / liver disease (nutritional + marrow toxicity factors).”
Stay updated with Hemostasis Today.
-
May 23, 2026, 05:38SIUH Advances Precision Stroke Care with Vena MicroAngioscope – Northwell Health
-
May 23, 2026, 05:31Kalyan Roy: Precision Blood Matching in Transfusion-Dependent Thalassaemia
-
May 23, 2026, 05:29Understanding Hepatitis A, B, and C During Hepatitis Awareness Month – UNC Health
-
May 23, 2026, 03:55WFH Initiative Brings Hope to the Hemophilia Community in India
-
May 23, 2026, 03:47Satyam Arora: Welcoming the New ISBT Board for the 2026 Term
-
May 23, 2026, 03:33Brig Tathagata Chatterjee: Connecting With World Leaders in Hematology at ISH Congress
-
May 23, 2026, 03:18Mathangi Kumar: Dental Management Strategies for Congenital Hemophilia
-
May 23, 2026, 03:02Maitri Vaishnav: Anatomical Variability and Surgical Relevance of Corona Mortis
-
May 23, 2026, 02:26Muhammad Hashim: When the Blood Smear Told a Different Story Behind a ‘Critical’ Platelet Count